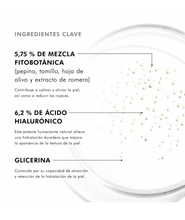

Bruma botánica hidratante que refuerza la barrera cutánea y reduce las rojeces visibles.
Una bruma facial hidratante clínicamente probada que refuerza la barrera cutánea y reduce inmediatamente las rojeces visibles. Una mezcla bótanica con extracto de pepino, tomillo, hojas de olico y romero que suaviza y calma la piel.
Contiene 6.2% de ácido hialurónico y glicerina que ayuda con la hidratación y retener agua en la piel.
50ml.